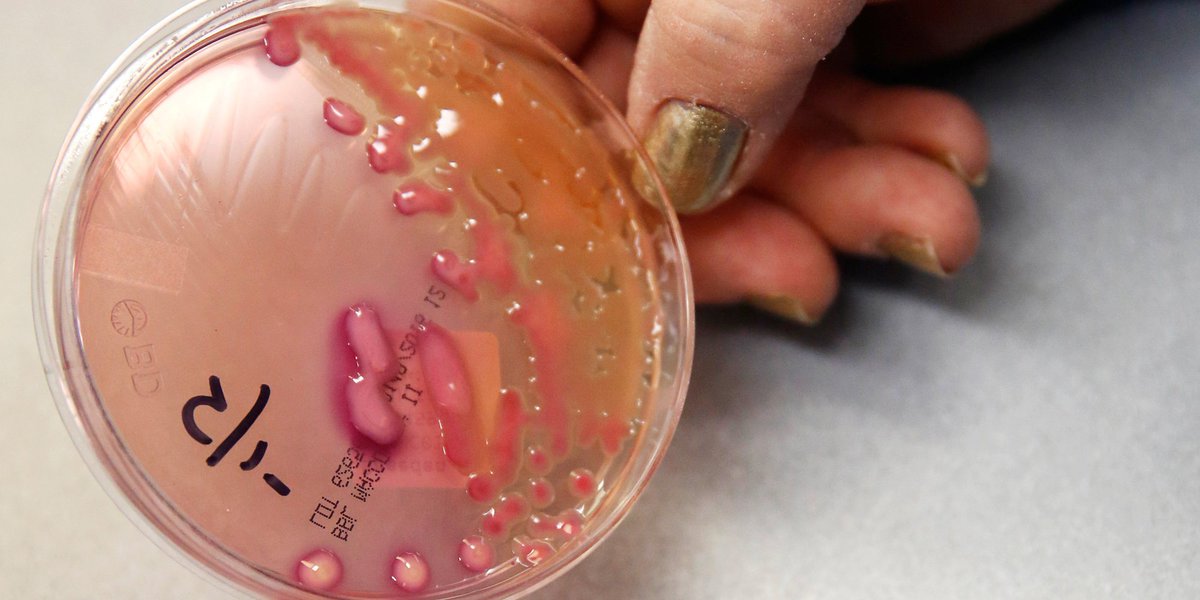

ಟ್ವೀಟ್ಗಳು
- ಟ್ವೀಟ್ಗಳು
- ಟ್ವೀಟ್ಗಳು & ಪ್ರತಿಕ್ರಿಯೆಗಳು
- ಮಾಧ್ಯಮ
@TheScope ತಡೆಹಿಡಿಯಲಾಗಿದೆ
ನೀವು ಖಚಿತವಾಗಿಯೂ ಈ ಟ್ವೀಟ್ಗಳನ್ನು ನೋಡಲು ಬಯಸುವಿರಾ? ಟ್ವೀಟ್ಗಳನ್ನು ನೋಡುವುದು @TheScope ಅವರನ್ನು ತಡೆತೆರವುಗೊಳಿಸುವುದಿಲ್ಲ.
-
ಪಿನ್ ಮಾಡಿದ ಟ್ವೀಟ್
Fentanyl, the drug implicated in Prince's death, is surging in communities hardest hit by opioids http://huff.to/2iaKAJu pic.twitter.com/IESEQaHIxK

-
Repealing the ACA could be a nightmare for mental health care http://huff.to/2jsjQVU pic.twitter.com/Mr8KvULIUQ

-
Why CDC head Tom Frieden is actually optimistic about public health under Trump http://huff.to/2jCiAgH pic.twitter.com/f56mar5RdW

-
"Speechless" tackles why people who are disabled aren’t inspirational http://huff.to/2jrIIwZ pic.twitter.com/VvPQcEXR4k

-
8 habits of activ vulnerable people http://huff.to/2jWOxE1 pic.twitter.com/a7X7wXBpLz

-
A woman has died from an infection resistant to every antibiotic we have http://huff.to/2iA2pCh pic.twitter.com/PDJiI6OPMU
-
Obamacare may have helped more poor people get breast cancer screenings http://huff.to/2igsHZL pic.twitter.com/R7UOERY4kS

-
Organ transplants hit a record high for a very depressing reason http://huff.to/2j2Ts4K pic.twitter.com/TGWUoNoO8s

-
Donald Trump’s health secretary pick is dividing America’s doctors http://huff.to/2iui6dR pic.twitter.com/k2MBqJC2pb

-
Donald Trump’s health secretary pick is dividing America’s doctors http://huff.to/2jt5WQU pic.twitter.com/500ZlVWEp6

-
Bernie Sanders: Donald Trump is right about Big Pharma http://huff.to/2jh5UOF pic.twitter.com/D0omxAY7ZR

-
Your drunken urge for pizza and wings, explained by science http://huff.to/2ity1cy pic.twitter.com/eGcxpbqdLl

-
Republicans would repeal Obamacare in precisely the way they accuse Democrats of enacting it http://huff.to/2jA0HCo pic.twitter.com/nrwBMeqINV

-
Newly discovered microbes show how humans evolved into complex organisms http://huff.to/2jtFC9o pic.twitter.com/27cwtkvd3p

-
Woman's death from infection resistant to every antibiotic in the U.S. shows rising threat http://huff.to/2ipO5bW pic.twitter.com/6WvfGKvn53

-
Donald Trump’s health secretary pick is dividing America’s doctors http://huff.to/2j9yYFM pic.twitter.com/klaXv21csg

-
Bernie Sanders: Donald Trump is right about Big Pharma http://huff.to/2ioUTGW pic.twitter.com/5VnjKy1vP9

-
New report shows the U.S. is failing when it comes to mental health http://huff.to/2iocxuk pic.twitter.com/JLnb3K0MaG

-
No, the weather isn't making your joints hurt more http://huff.to/2iokXSF pic.twitter.com/lOUHb0Bgvr

-
Being a musician is good for your brain http://huff.to/2islCp7 pic.twitter.com/3GJvxT7UBX

-
These science-backed tips will help you demolish your to-do list http://huff.to/2iPxob8 pic.twitter.com/rknz5NqZND

ಲೋಡಿಂಗ್ ಸಮಯ ಸ್ವಲ್ಪ ತೆಗೆದುಕೊಳ್ಳುತ್ತಿರುವಂತೆನಿಸುತ್ತದೆ.
Twitter ಸಾಮರ್ಥ್ಯ ಮೀರಿರಬಹುದು ಅಥವಾ ಕ್ಷಣಿಕವಾದ ತೊಂದರೆಯನ್ನು ಅನುಭವಿಸುತ್ತಿರಬಹುದು. ಮತ್ತೆ ಪ್ರಯತ್ನಿಸಿ ಅಥವಾ ಹೆಚ್ಚಿನ ಮಾಹಿತಿಗೆ Twitter ಸ್ಥಿತಿಗೆ ಭೇಟಿ ನೀಡಿ.


 The Scope
The Scope